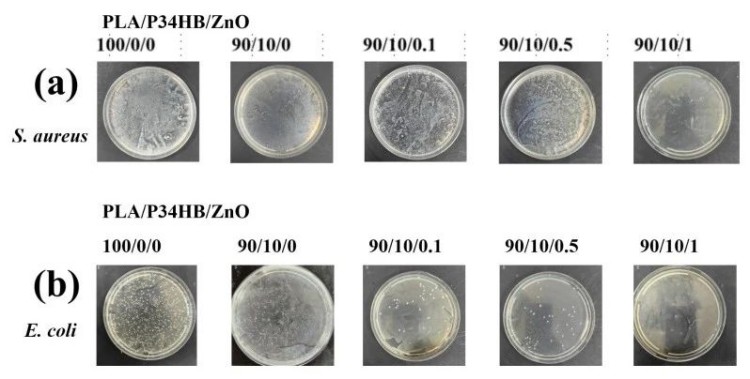
1751386153116607.jpg 2.4.jpg

报告分享 | 长春应化所张会良:《PLA复合熔喷无纺布开发》
熔喷非织造布因其独特的超细纤维结构和优异的过滤、吸附等特性,在空气净化、医用防护、油水分离等领域具有广泛的应用。
然而,目前工业上主流的熔喷材料如聚丙烯(PP)难以降解,带来了严重的环境污染问题。因此,开发高性能、可生物降解的熔喷非织造材料成为研究热点。
聚乳酸(PLA)作为一种来源于可再生资源的生物可降解高分子材料,凭借其良好的生物相容性和机械性能,成为替代PP的重要候选材料。
然而,PLA在熔喷加工过程中存在熔体流动性差、脆性较大、热稳定性低等问题,限制了其在熔喷领域的进一步应用。
如何让PLA满足无纺布产业化应用的需求?
在第十届生物基大会的可持续应用论坛-生物基纤维-面料&非织造布专场上,中国科学院长春应用化学研究所 研究员 张会良 分享了题为《PLA复合熔喷无纺布开发》研究报告。
本研究围绕PLA熔喷非织造布的成形机理、结构调控及功能化改性展开,
目的是提升PLA熔喷材料的可加工性、力学性能、耐久性及功能化特性,拓展其在高端过滤及医用防护领域的应用潜力。

经过张会良老师同意,DT产研院将研究的主要结论分享如下:
01
PLA的分子量对无纺布性能的影响
本研究选用了的不同分子量的PLA(Modified PLA-290、PLA-290、PLA-4032D、PLA-2003D)为原料,也选用Sn(Oct)2作为降解剂对PLA-290进行降解,进一步降低分子量。
不同分子量在熔喷成形过程中表现出不同的熔体流变行为和纤维成形特性。
系统研究了熔喷非织造布的相态形貌、流变行为、疏水特性和结晶特性。
热力学和结晶行为研究表明,低分子量PLA熔喷非织造布具有更高的结晶度,同时POM分析表明在相同结晶时间内,低分子量样品可获得更大的球晶尺寸。
流变学测试显示,随着分子量增加,储能模量(G′)、损耗模量(G′′)和复数黏度|η*|均呈现上升趋势。
SEM观察显示纤维平均直径从11.86μm增加至21.07 μm。
此外,由于黏度增加导致纤维直径分布范围扩大。熔喷非织造布的水接触角WCA从128.9°下降至114.9°。

PLA熔喷非织造布扫描电镜图,图片来源:张会良《PLA复合熔喷无纺布开发》
02
PLA/PBAT无纺布的制备和研究
本研究采用熔喷技术制备了具有优异油水分离性能的聚乳酸/聚己二酸-对苯二甲酸丁二酯(PLA/PBAT)熔喷非织造布。
探讨了不同PBAT含量(0、2、4、6、8、10 wt%)对PLA/PBAT熔喷非织造布的热性能、结晶性能、形貌结构、力学性能、润湿性及油水分离性能的影响。
DSC和WAXD结果表明,PBAT的引入促进了PLA分子链的运动,提高了PLA的结晶度。
随着PBAT含量的增加,PLA的熔融焓从38.1 J/g提升至55.1 J/g,结晶度由1.5%提高至15.5%,均显著高于纯PLA。
此外,PBAT的加入增强了PLA熔喷非织造布的韧性和疏水性,其中PLA/PBAT 90/10熔喷非织造布的断裂伸长率(53.3 ± 3.7%)。
在油水分离测试中,PLA/PBAT熔喷非织造布能够有效分离染色环己烷和染色水溶液。
当PBAT含量增加至10 wt%时,熔喷非织造布的水接触角由122.3°增加至133.2°,表现出更优异的疏水性。
此外,PLA/PBAT熔喷非织造布的环己烷吸附能力达5.18g/g,且在5次循环测试后,分离效率仍可保持在96%以上。
这表明,该材料具有良好的油水分离能力和重复使用性能,可作为生物降解型吸油材料。

(a)PLA/PBAT熔喷非织造布环己烷吸附实验;(b)油水分离性能, (A)100/0, (B) 98/2, (C) 96/4, (D) 94/6, (E) 92/8, and (F) 90/10,图片来源:张会良《PLA复合熔喷无纺布开发》
03
高稳定性PLLA/PDLA无纺布的制备和研究
本研究通过熔融共混与熔喷工艺制备了聚左旋乳酸(PLLA)/聚右旋乳酸(PDLA)熔喷非织造材料,
系统探究了其结构、热性能、热稳定性、生物降解性及结晶形貌。
结果表明,PDLA的引入促进了PLLA基体中立构复合晶体(SC)的形成,SC晶体作为物理交联点显著提升了熔喷非织造布的G'、G''和|η*|。
同时,SC晶体的致密堆积与氢键作用有效提升了材料的热稳定性,
随着PDLA含量的增加,T10% 由277.5°C提升至342.4°C,最大热降解速率对应的温度由324.7°C提高至385.5°C。
此外,PLLA/PDLA熔喷非织造布的疏水性显著改善,水接触角从127.1°升至139.7°,
并在酶降解实验中表现出较高的抗水解能力,在保持较高生物降解效率的同时兼顾了材料的耐久性。
通过SEM分析纤维形貌,SC晶体的引入,提高了熔体粘度,进而使纤维的平均直径由9.6μm增至16.4μm。
04
PLA/P34HB/ZnO抗菌无纺布的制备研究
在空气过滤和医用防护领域,熔喷非织造布的抗菌性能和过滤性能至关重要。
本研究通过引入聚3-羟基丁酸(P34HB)与氧化锌(ZnO),赋予PLA熔喷非织造布优异的抗菌性和高效过滤特性。
研究发现,PLA/P34HB/ZnO熔喷非织造布对金黄色葡萄球菌(S. aureus)和大肠杆菌(E. coli)的抑制效果明显。
GPC和流变测试结果表明,ZnO可促进PLA的降解,使分子量和复数黏度降低,同时熔融指数增加,从而改善PLA的可纺性。
DSC研究结果表明,在一次升温过程中,加入了P34HB促进了PLA的冷结晶,在降温过程中,ZnO的加入对结晶过程起到了先促进后抑制的作用。
通过SEM分析,当ZnO含量为1 wt%时,纤维的平均直径为4.8μm。
过滤测试结果显示,该材料对粒径为10μm的颗粒过滤效率超过80%,表明其适用于空气过滤应用。
这一研究为高性能抗菌过滤材料的开发提供了新的技术路径。
PLA/P34HB/ZnO熔喷非织造布的抗菌性能,图片来源:张会良《PLA复合熔喷无纺布开发》
本研究围绕PLA熔喷非织造布的制备及改性展开系统研究,通过优化PLA分子量、PBAT共混改性、PLLA/PDLA立构复合、P34HB和ZnO功能化等策略,显著改善了PLA熔喷非织造布的加工性能、力学性能、耐久性及功能化特性。
研究成果明确了PLA基熔喷材料的结构-性能关系,为其规模化生产及应用提供了理论依据和技术支撑,本研究对推动可持续、高性能生物降解熔喷非织造材料的开发具有重要的学术和产业价值。
05
未来研究方向展望
(1)研究PLA的熔喷工艺,提升纤维的细度、均匀性和成形稳定性;
(2)研究PLA熔喷材料的长期降解行为,探索其在不同环境条件下的服役寿命;(3)结合纳米材料及智能功能材料,开发高效驻极、催化降解、自清洁等多功能熔喷非织造布,以满足日益增长的高端空气过滤与医用防护需求。
产学研合作
张会良研究员团队开放技术合作,欢迎联系!
邮箱:hlzhang@ciac.ac.cn
▌参考信息:本文部分素材来自张会良研究员,由DT新材料重新编写,系作者个人观点,本平台发布仅为了传达一种不同观点,不代表对该观点赞同或支持。如果有任何问题,请联系我们:18094560191(微信同号)
